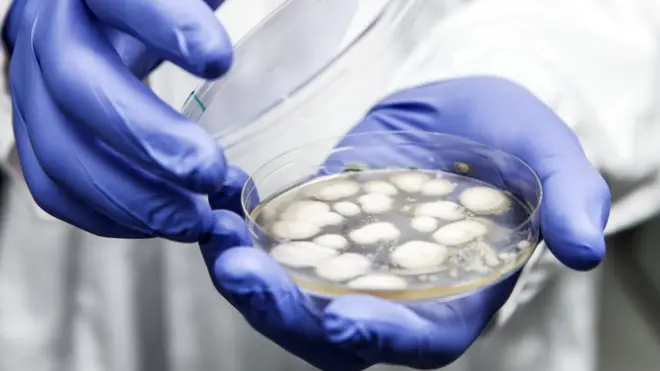
Moho de penicilina

El mundo es vulnerable a una gran epidemia, le dice Bill Gates a la BBC

Fuente de la imagen, Getty Images
- Autor, Redacción
- Título del autor, BBC Mundo
"Mantengo los dedos permanentemente cruzados para que no nos llegue una gran epidemia como la gripe en los próximos diez años".
Esa es la gran preocupación de Bill Gates, fundador de la empresa Microsoft y benefactor de programas globales para la erradicación de enfermedades a través de la Fundación Bill y Melinda Gates.
El filántropo expresó confianza en que el mundo tendrá mejores herramientas y mejores maneras de responder pero que, actualmente estamos un tanto vulnerables a que una infección mortal se propague muy rápidamente.
"Eso sería una tragedia", declaró al programa de radio Today, de la BBC.
El riesgo se debe principalmente al uso excesivo de antibióticos que ha generado bacterias resistentes a esos fármacos y, según Gates, se necesita un esfuerzo mundial coordinado para desarrollar nuevos métodos y nuevos fármacos para reducir esa amenaza.
"La salud nos afecta a todos. Si no descubrimos nuevos medicamentos, la salud de todos nosotros estará en riesgo. Es muy importante recordarle eso al público", sentenció.
De los antibióticos a las superbacterias
La ironía es que uno de los mayores adelantos de la ciencia en el siglo XX es ahora una de las mayores amenazas en potencia contra la salud del siglo XXI.
Los antibióticos nos han protegido de morir por infecciones menores pero su uso excesivo y, algunas veces, abuso, ha generado bacterias resistentes a casi todos estos tratamientos.

Fuente de la imagen, Science Photo Library
Nuevos fármacos tendrán que ser creados para combatir las llamadas superbacterias resistentes.
Es una de las grandes preocupaciones de muchos profesionales de la salud y de organizaciones que combaten la propagación de epidemias.
193 países acordaron en Naciones Unidas sobre la necesidad de tomar acción global al respecto.
"Algunas veces, cuando logramos un gran éxito, como con los antibióticos, nos volvemos complacientes", explicó Gates. "Las bacterias entonces evolucionan en torno a esos fármacos que hemos estado usando tal vez demasiado tanto en humanos como en animales".
Como muchos asuntos que tienen que ver con la salud,ésta situación es más grave en países menos desarrollados. Pero, aún en Estados Unidos y Reino Unido, se ven pacientes que han tenido una operación de rutina y luego sufren de una infección que no puede ser tratada.

Fuente de la imagen, Science Photo Library
Muchos expertos de la salud identifican a India como uno de los principales focos de la creciente resistencia a los antibióticos. Allí, el uso de estos medicamentos es descontrolado, aún en bebés prematuros.
"La mayoría de los antibióticos que entraron en uso en los últimos 30 a 40 años han creado algún tipo de resistencia. Otros son de un tipo que la resistencia bacteriana se crea tan rápidamente que, en el término de un año, son prácticamente inútiles para nosotros", dijo el doctor Krishan Chugh, director de pediatría de Instituto de Investigación Fortis Memorial, en Nueva Delhi.
Los científicos están descubriendo lo fácil que esa resistencia puede ser pasada de una bacteria a otra.
Es un intercambio de información genética ni siquiera tiene que suceder dentro del cuerpo humano, puede suceder en un charco de agua afuera entre organismos que no están relacionados.
Rápida propagación
Un muy buen ejemplo de una cepa que surge en un lugar y luego se extiende por todas partes es la NDM-1 (New Delhi metallo-beta-lactamase) que resiste a los antibióticos betalactámicos.
Surgió posiblemente por primera vez en un paciente indio en 2010. La cepa se propagó a Suecia y ahora se encuentra en más de 110 países en el mundo, incluyendo Reino Unido.
Y no sólo se encuentra en infecciones. La NDM-1 se ha encontrado en microbios en el río Ganges y, de acuerdo a un estudio, hasta en el acueducto de la ciudad.

Fuente de la imagen, AP
Eso se debe a la producción masiva e incontrolada de antibióticos, según Anu Agarwal es una experta en contaminación ambiental con la organización activista Toxics Link.
"Lo que hacemos aquí y en China es producción en masa y cuando se fabrica en masa hay mucho desperdicio. Si los antibióticos se arrojan al medio ambiente, los microorganismos tiene la oportunidad de desarrollar resistencia contra estos.", aseguró Agarwal.
También hay muy poco control sobre el uso de antibióticos en la industria agrícola. Los residuos antibióticos se han encontrado en aves, en la leche y en la miel de India.
Cómo impedir el uso excesivo de antibióticos en animales es para Bill Gates uno de los problemas donde se deben coordinar los esfuerzos.
Hay un uso rutinario de suministrarle antibióticos a un animal aun cuando no esté enfermo, señaló Gates.
Se pensaba que eso reducía las enfermedades o que fomentaba mayor crecimiento. Sin embargo, ahora en Europa esencialmente se ha prohibido la práctica.

Fuente de la imagen, Getty Images
"Con eso tendremos unos años para ver si eso ayuda a reducir esta resistencia antimicrobiana. Así podremos convencer a EE.UU. y a China y otros países de que hay antibióticos muy avanzados que no pueden ser utilizados. Eso ayudará", dijo Gates a la BBC.
Pero reduciendo el uso en animales será suficiente.
"Tras ver lo que ha sucedido con el ébola y el zika nos damos cuenta que no hemos hecho lo suficiente", afirmó.

Fuente de la imagen, Getty Images
"Nuestra habilidad de crear nuevos fármacos y vacunas rápidamente, cuando tenemos una enfermedad que crea emergencia... no está muy desarrollada".
Tampoco lo están los métodos de investigación y desarrollo, ni los sistemas para movilizar el personal experto a los focos de las epidemias y frenarlas.
"Hay mucha discusión en estos momentos sobre cómo responderemos a una emergencia. Cómo nos aseguramos de que los límites regulatorios, organizacionales y jurídicos no nos entorpezcan", añadió el filántropo.
A pesar de que entes como la Organización Mundial de la Salud (OMS) fue muy criticada por su reacción a la epidemia del ébola, Bill Gates pone mucha fe en los esfuerzos multilaterales.

Fuente de la imagen, SCIMAT/SCIENCE PHOTO LIBRARY
"Es muy importante que no nos olvidemos de que el mundo trabajó conjuntamente para eliminar la viruela, y estamos muy cerca de eliminar la polio", aseguró.
Es una cooperación que debe intensificarse, es la única manera que los problemas globales se podrán resolver, según Gates.
A pesar de que haya un sentimiento negativo hacia la OMS, el mensaje no debe ser que esos esfuerzos multilaterales no son efectivos y que el dinero es malgastado, sino, por el contrario, se debe ampliar su capacidad para concentrarnos otra vez en la cooperación.
"Los países más ricos tienen la capacidad, tienen grandes epidemiólogos, científicos y si no nos involucramos, estas epidemias llegarán a nuestros países", advirtió.
"No es sólo la meta humanitaria, también hay un interés propio de lograr seguridad de salud a nivel global".